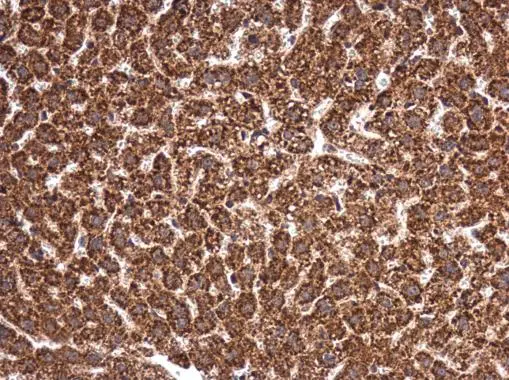
MANEA antibody detects MANEA protein at cytoplasm in mouse liver by immunohistochemical analysis. Sample: Paraffin-embedded mouse liver. MANEA antibody (GTX122518) diluted at 1:500. 
 Antigen Retrieval: Citrate buffer, pH 6.0, 15 min

Immunohistochemical staining of human colon, kidney, liver and testis using Anti-MANEA antibody HPA011069 (A) shows similar protein distribution across tissues to independent antibody HPA011046 (B).
Anti-MANEA Antibody
HPA011069
ApplicationsImmunoHistoChemistry
Product group Antibodies
ReactivityHuman
TargetMANEA
Overview
- SupplierAtlas Antibodies
- Product NameAnti-MANEA Antibody
- Delivery Days Customer4
- ApplicationsImmunoHistoChemistry
- CertificationResearch Use Only
- ClonalityPolyclonal
- ConjugateUnconjugated
- Gene ID79694
- Target nameMANEA
- Target descriptionmannosidase endo-alpha
- Target synonymsENDO, hEndo, glycoprotein endo-alpha-1,2-mannosidase, alpha 1,2-endomannosidase, endo-alpha mannosidase, endomannosidase, mandaselin
- HostRabbit
- IsotypeIgG
- Protein IDQ5SRI9
- Protein NameGlycoprotein endo-alpha-1,2-mannosidase
- Scientific DescriptionRecombinant Protein Epitope Signature Tag (PrEST) antigen sequence
- ReactivityHuman
- Storage Instruction-20°C,2°C to 8°C
- UNSPSC41116161